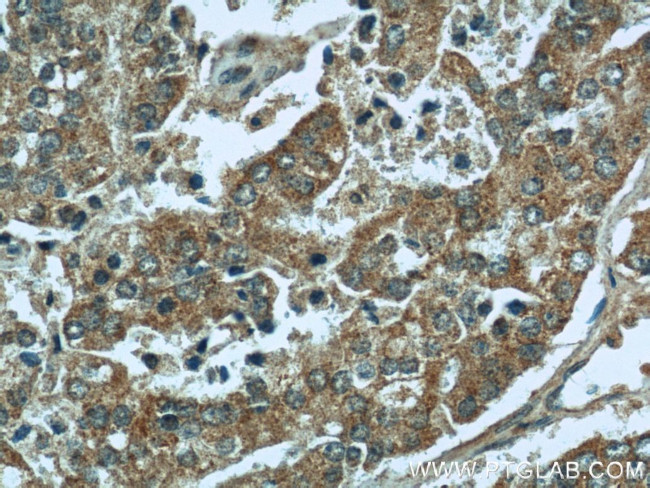
MAPKSP1 Antibody in Immunohistochemistry (Paraffin) (IHC (P))
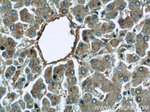
MAPKSP1 Antibody in Immunohistochemistry (Paraffin) (IHC (P))

Search
Proteintech
MAPKSP1 Polyclonal Antibody
{{$productOrderCtrl.translations['antibody.pdp.commerceCard.promotion.promotions']}}
{{$productOrderCtrl.translations['antibody.pdp.commerceCard.promotion.viewpromo']}}
{{$productOrderCtrl.translations['antibody.pdp.commerceCard.promotion.promocode']}}: {{promo.promoCode}} {{promo.promoTitle}} {{promo.promoDescription}}. {{$productOrderCtrl.translations['antibody.pdp.commerceCard.promotion.learnmore']}}
产品信息
11937-1-AP
种属反应
宿主/亚型
分类
类型
抗原
偶联物
形式
浓度
规格
纯化类型
保存液
内含物
保存条件
运输条件
产品详细信息
Immunogen sequence: MADDLKRFL YKKLPSVEGL HAIVVSDRDG VPVIKVANDN APEHALRPGF LSTFALATDQ GSKLGLSKNK SIICYYNTYQ VVQFNRLPLV VSFIASSSAN TGLIVSLEKE LAPLFEELRQ VVEVS (1-124 aa encoded by BC026245)
靶标信息
This gene encodes a scaffold protein that functions in the extracellular signal-regulated kinase (ERK) cascade. The protein is localized to late endosomes by the mitogen-activated protein-binding protein-interacting protein, and binds specifically to MAP kinase kinase MAP2K1/MEK1, MAP kinase MAPK3/ERK1, and MAP kinase MAPK1/ERK2. Studies of the orthologous gene in mouse indicate that it regulates late endosomal traffic and cell proliferation. Alternatively spliced transcript variants encoding multiple isoforms have been observed for this gene. A pseudogene of this gene is located on the long arm of chromosome 13.
仅用于科研。不用于诊断过程。未经明确授权不得转售。
生物信息学
蛋白别名: Late endosomal/lysosomal adaptor and MAPK and MTOR activator 3; MAPK scaffold protein 1; Mek; MEK binding partner 1; MEK partner 1; MEK-binding partner 1; mitogen activated protein, binding protein; mitogen-activated protein kinase kinase 1 interacting protein 1; Mitogen-activated protein kinase kinase 1-interacting protein 1; Mitogen-activated protein kinase scaffold protein 1; Mp1; Ragulator complex protein LAMTOR3; unnamed protein product
基因别名: AW556229; LAMTOR3; MAP2K1IP1; MAPBP; MAPKSP1; MP1; PRO0633; PRO2783; Ragulator3
UniProt ID: (Human) Q9UHA4, (Rat) Q5U204, (Mouse) O88653
Entrez Gene ID: (Human) 8649, (Rat) 362045, (Mouse) 56692